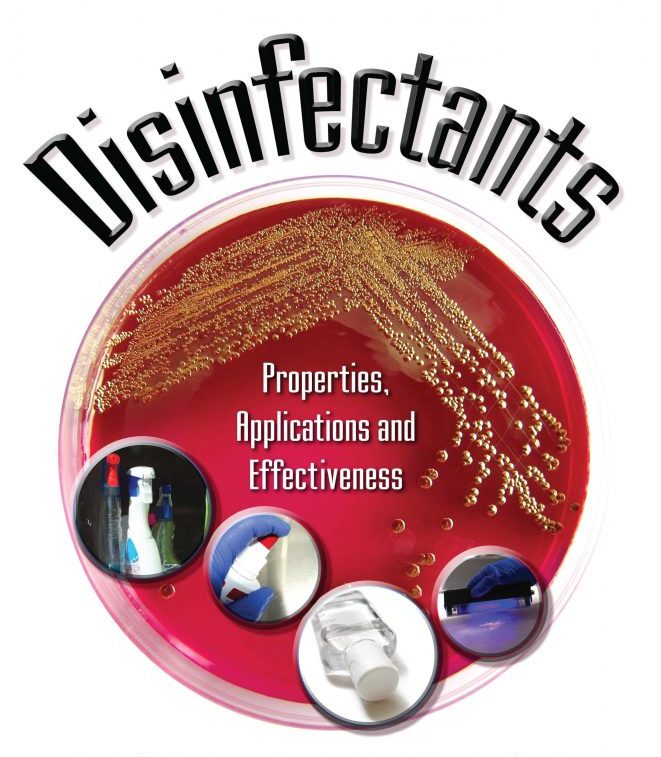

Protecting Health, Preventing Infections, Promote hygiene
At Seydox Laboratories, we are committed to safeguarding health by preventing infections. As a research-driven manufacturer, we specialize in high-quality disinfectants, cleaning agents, and care products tailored for the Pharmaceutical, nutraceutical, food industry, general industry, dental and medical sectors. Our mission is to support healthcare professionals—dentists, doctors, nurses, and medical staff—in their vital work by providing fast-acting, reliable, and safe solutions effective against a broad spectrum of viruses, bacteria, and fungi.
Why Choose Seydox?
Our state-of-the-art laboratories focus on developing environmentally friendly products with high material compatibility.
So many industries rely on our products for infection control.
Our dedicated professionals ensure that every product meets international standards for safety and efficacy.
About us
Our Journey
Since our inception, Seydox Laboratories has been at the forefront of infection control solutions. Our dedicated research teams work tirelessly to develop innovative products, improve existing formulas, and conduct rigorous microbiological testing. We ensure that all our disinfectants meet international standards, providing maximum protection against disease transmission.
Our Commitment
Every product undergoes stringent quality checks to ensure effectiveness and safety.
We prioritize eco-friendly practices in our manufacturing processes.
Our products are designed with the needs of healthcare professionals in mind, ensuring ease of use and reliability.

Products
Our Product Range
Explore our comprehensive range of disinfectants and cleaning solutions designed for various applications:
- 1. Instrument Disinfectants: Specialized solutions for the sterilization of medical and dental instruments.
- 2. Surface Disinfectants: Effective against a wide range of pathogens, ensuring clean and safe environments.
- 3. Hand Hygiene Products: Gentle yet effective hand sanitizers,hand rub,skin cleaner and soaps for frequent use.
- 4. Lubricants, rust remover and general cleaning.
1- Instrument Disinfectants
Specialized solutions for the sterilization of medical and dental instruments.
2- Surface Disinfectants
Effective against a wide range of pathogens, ensuring clean and safe environments.
3- Hand Hygiene Products
Gentle yet effective hand sanitizers,hand rub,skin cleaner and soaps for frequent use.
4- Lubricants
Rust remover and general cleaning.
Products
Our Product Range
Explore our comprehensive range of disinfectants and cleaning solutions designed for various applications:

Careers
Join Our Team
At Seydox Laboratories, we believe in connecting the right people to the right opportunities. We are always on the lookout for talented professionals passionate about making a difference in healthcare.

Why Work With Us?
Growth Opportunities
We provide avenues for professional development and career advancement.
Inclusive Culture
Our diverse team fosters a collaborative and supportive work environment.
Impactful Work
Contribute to products that play a crucial role in global health.
Contact Us
Get in Touch
We value your interest in Seydox Laboratories. For inquiries, feedback, or support, please reach out to us through e-commerce website or through the following channels:
Call Us
+92 300 0337972
Email Us
info@seydox.com
sales@seydox.com
Address
FB Industrial Area Karachi
Business Hours
Mon - Sat 09:00 AM to 06:00 PM
Testimonials
What they say about us
Senectus nisi congue netus posuere volutpat cras nascetur risus.



Don’t Lose Hope, There’s Always A Company Looking For You

Our Core Products
Discover Seydox’s Most Trusted Products
Seydox Enzymatic X Plus
Seydox Zyme Detergent
Seydox Instrument Disinfectant X Plus
High-level disinfectant formulated for the safe and efficient sterilization of all types of reusable instruments.
Seydox Instrument Disinfectant X-11
Rapid-action surface disinfectant with broad-spectrum antimicrobial efficacy.
Seydox Instrument Disinfectant X-21
Seydox Instrument Disinfectant X-31
High-performance disinfectant suitable for areas with a high risk of contamination.
Seydox Instrument Disinfectant X-41
Versatile cleaner and disinfectant with a strong safety profile for both instruments and surfaces.
Seydox Instrument Disinfectant R-Plus
Seydox 91
Heavy Duty Cleaner, Degreaser & Disinfectant is a powerful, multi-purpose solution designed for removing tough grease, grime, and dirt from various surfaces. It effectively cleans, disinfects, and deodorizes in one step
Seydox Liquid Hand Disinfectant
Fast-drying, skin-friendly hand sanitizer providing maximum protection with frequent use.
Seydox Surface 1X
Ready-to-use surface disinfectant with quick action and high material compatibility.
Seydox Surface 2X
Concentrated surface disinfectant for large-scale disinfection with long-lasting efficacy.
F. A. Q
Frequently Asked Questions
Welcome to Seydox’s F.A.Q section.
Here you’ll find answers to the most commonly asked questions about our services. We’ve made this section to help you get quick and clear information.
Yes, our products are developed with a focus on environmental sustainability and safety.
You can contact our sales team via phone or email, or fill out the contact form on our website.
Yes, we provide bulk purchasing options.
All our products are manufactured in our state-of-the-art facilities, adhering to international quality standards and qualification protocols.
